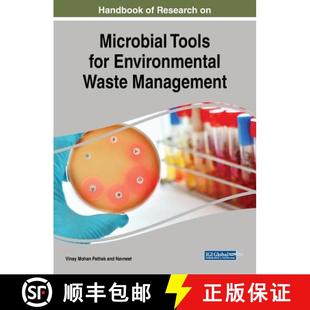

Agro Biocomposites Waste Applications Biopolymers Packaging 4周达 9780128199534 and for from
¥2665满500减50售0件

United 9781620813126 Needs Management 4周达 Strategies Nuclear States Future Waste and Critical
¥2672满500减50售0件

Concrete 9780857096821 4周达 Waste Demolition and Recycled Handbook
¥2672满500减50售0件

Non Conventional Treatment 9781621000792 Water 4周达 Waste Textile
¥2672满500减50售0件

Municipal 9781536134414 Sourc... Management 4周达 Practices Industrial and Challenges Waste Future Sources
¥2672满500减50售0件

Renewable 9783031065613 Handbook Biorefinery Circular Waste 4周达 Energy Economy
¥2673满500减50售0件

Demolition Advances Management 9780443239625 Technologies Construction 4周达 Recycling Waste and ... Digital
¥2689满500减50售0件

Basic 4周达 Hazardous Waste 9781566705332 Management
¥2690满500减50售0件

Concise Handbook Technologies 9780367631307 Treatment 4周达 Waste
¥2690满500减50售0件

Waste 4周达 Energy 9781536144314 WtE
¥2693满500减50售0件

Industry Economy Circular for F... Sustainable 9781536149951 4周达 Construction Waste the Profit
¥2693满500减50售0件

ROUTLEDGE HANDBOOK WASTE 4周达 FOOD 9781138615861
¥2698满500减50售0件

Vol. 9789351309130 Waste Environmental Processes 3周达 Treatment Engineering
¥2698满500减50售0件

Vol. 9789351309116 Waste Environmental Processes 3周达 Treatment Engineering
¥2698满500减50售0件

and Handbook Artificial 9780128217306 Recycled Sustainable 4周达 Waste Industrial Concrete ... Management
¥2698满500减50售0件

Vol. 9789351309147 Waste Environmental Processes 3周达 Treatment Engineering
¥2698满500减50售0件

Waste 9781566767675 Treatment Engineering Processes 预订Industrial
¥5472满800减100售0件

Handbook 4周达 Waste 9780857936851 Management
¥2751满500减50售0件

Reuse Water Low from Models Energy Business and Waste 9781138016552 ... Resource 4周达 Nutrient Recovery for
¥2754满500减50售0件

Ensuring Managing Quality Waste Brewing Valorising 4周达 9781782423317 Microbiology and Microbes
¥2760满500减50售0件

Treated and 处理水和废水 色谱分析 天然水 Natural Waters 海外直订Chromatography Waste
¥5528满999减100售0件

Challenges Management Solutions Wiley土木工程 Radioactive Opportunities 4周达 9781860582769 Waste And 2000
¥2765满500减50售0件

The Routledge Studies 9780367894207 Waste 4周达 Handbook
¥2778满500减50售0件

Hazardous 4周达 Waste Cost 9780824788919 Control
¥2780满500减50售0件

Water Quality 9781780401232 Animal Health Waste Human 预订 and
¥2784满500减50售0件
Handbook 9781522535409 Management Tools 4周达 for Research Waste Environmental Microbial
¥2786满500减50售0件

Ensuring Managing Quality Waste Brewing Valorising 4周达 9780323996068 Microbiology and Microbes
¥2798满500减50售0件

Management Waste Practices for Sustai Environmental Zero
¥1129.2满198减20售0件

Waste 9781315895161 4周达 Handbook Practical Hazardous Industrial Managing
¥2824满500减50售0件

9798369342640 4周达 Contexts Development Sustainable Management Waste Exploring
¥2830满500减50售0件